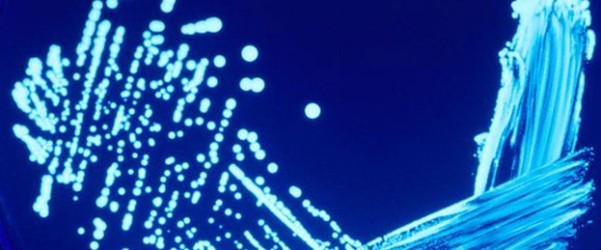
Nuevo alcance de ENAC

El Blog de AQM Laboratorios
Nuevo alcance de ENAC
En días pasados hemos renovado y ampliado nuestro alcance de la Acreditación de ENAC, teniendo ahora acreditados la Detección y Recuento de Legionella spp según la UNE-EN ISO 11731:2007 en aguas de consumo y aguas continentales tratadas no destinadas al consumo humano, el recuento de enterococos en aguas de consumo…
Continuar leyendo →Millones de personas en el mundo carecen de agua potable
Acabo de leer un artículo muy interesante en water.org sobre la falta de acceso al agua en el mundo y me hace reflexionar sobre lo poco que se valora en muchas ocasiones el tratamiento adecuado del agua en España y llevar los controles de análisis adecuados. En muchas ocasiones oigo decir a…
Continuar leyendo →4 brotes de Legionella en el Centro de Control de AENA
Aena ha ocultado durante nueve meses la existencia de cuatro brotes de Legionella en el Centro de Control de Tránsito Aéreo de Torrejón de Ardoz, el lugar desde el que se controla la navegación aérea de Madrid y de gran parte de España. La noticia de los brotes de…
Continuar leyendo →